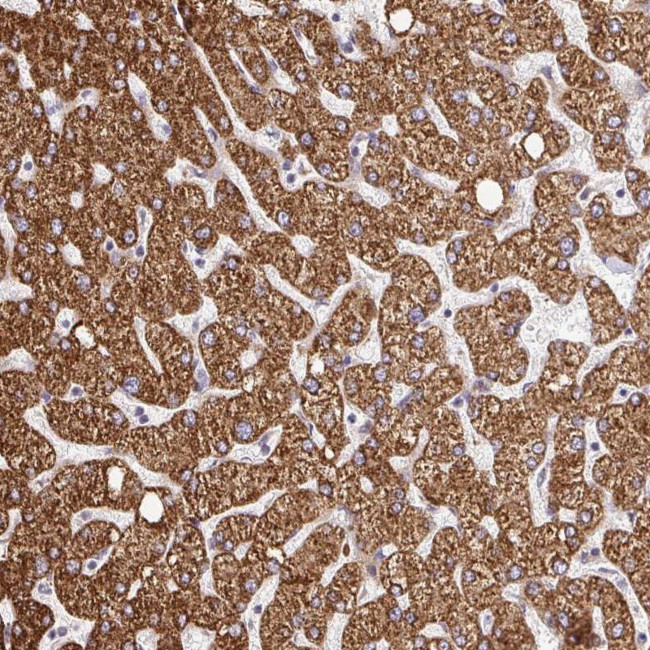
RHEBL1 Antibody in Immunohistochemistry (Paraffin) (IHC (P))

Search
Invitrogen
RHEBL1 Polyclonal Antibody
{{$productOrderCtrl.translations['antibody.pdp.commerceCard.promotion.promotions']}}
{{$productOrderCtrl.translations['antibody.pdp.commerceCard.promotion.viewpromo']}}
{{$productOrderCtrl.translations['antibody.pdp.commerceCard.promotion.promocode']}}: {{promo.promoCode}} {{promo.promoTitle}} {{promo.promoDescription}}. {{$productOrderCtrl.translations['antibody.pdp.commerceCard.promotion.learnmore']}}

Please note: We are reviewing Western blot images included in the antibody testing data in our catalog, including those provided by third parties. Unless expressly labeled or annotated as “raw-unedited”, Western blot images included in the antibody testing data in our catalog may have been edited, optimized or otherwise adjusted for presentation.
产品信息
PA5-63919
种属反应
宿主/亚型
分类
类型
抗原
偶联物
形式
浓度
规格
纯化类型
保存液
内含物
保存条件
运输条件
RRID
产品详细信息
Immunogen sequence: SSARENQLTQ GIFTKVIQEI ARVENSYGQE RRCHLM
Highest antigen sequence identity to the following orthologs: Mouse - 81%, Rat - 81%.
靶标信息
RhebL1 (ras homolog enriched in brain-like protein 1), also known as Rheb2 or GTPase RhebL1, is a 183 amino acid protein that belongs to the small GTPase superfamily and Rheb family. Localizing to the cell membrane as well as the cytoplasm, RhebL1 is ubiquitously expressed and is increased two-fold in many tumor cell lines. RhebL1 exhibits GTPase activity and may activate NF-kappa-B-mediated gene transcription. Regulating the activity of Rictor, RhebL1 also promotes signal transduction. RhebL1 exists as two alternatively spliced isoforms and is encoded by a gene that maps to human chromosome 12q13.12 and mouse chromosome 15 F1. Human chromosome 12 encodes over 1,100 genes and comprises approximately 4.5% of the human genome. Chromosome 12 is associated with a variety of diseases and afflictions, including hypochondrogenesis, achondrogenesis, Kniest dysplasia, Noonan syndrome and trisomy 12p, which causes facial developmental defects and seizure disorders. Binds GTP and exhibits intrinsic GTPase activity. May activate NF-kappa-B-mediated gene transcription. Promotes signal transduction through MTOR, activates RPS6KB1, and is a downstream target of the small GTPase-activating proteins TSC1 and TSC2.
仅用于科研。不用于诊断过程。未经明确授权不得转售。
篇参考文献 (0)
生物信息学
蛋白别名: GTPase RhebL1; Ras homolog enriched in brain like-1 c; Ras homolog enriched in brain-like protein 1; Rheb-like protein 1; Rheb2; RhebL1c
基因别名: RHEBL1
Entrez Gene ID: (Human) 121268